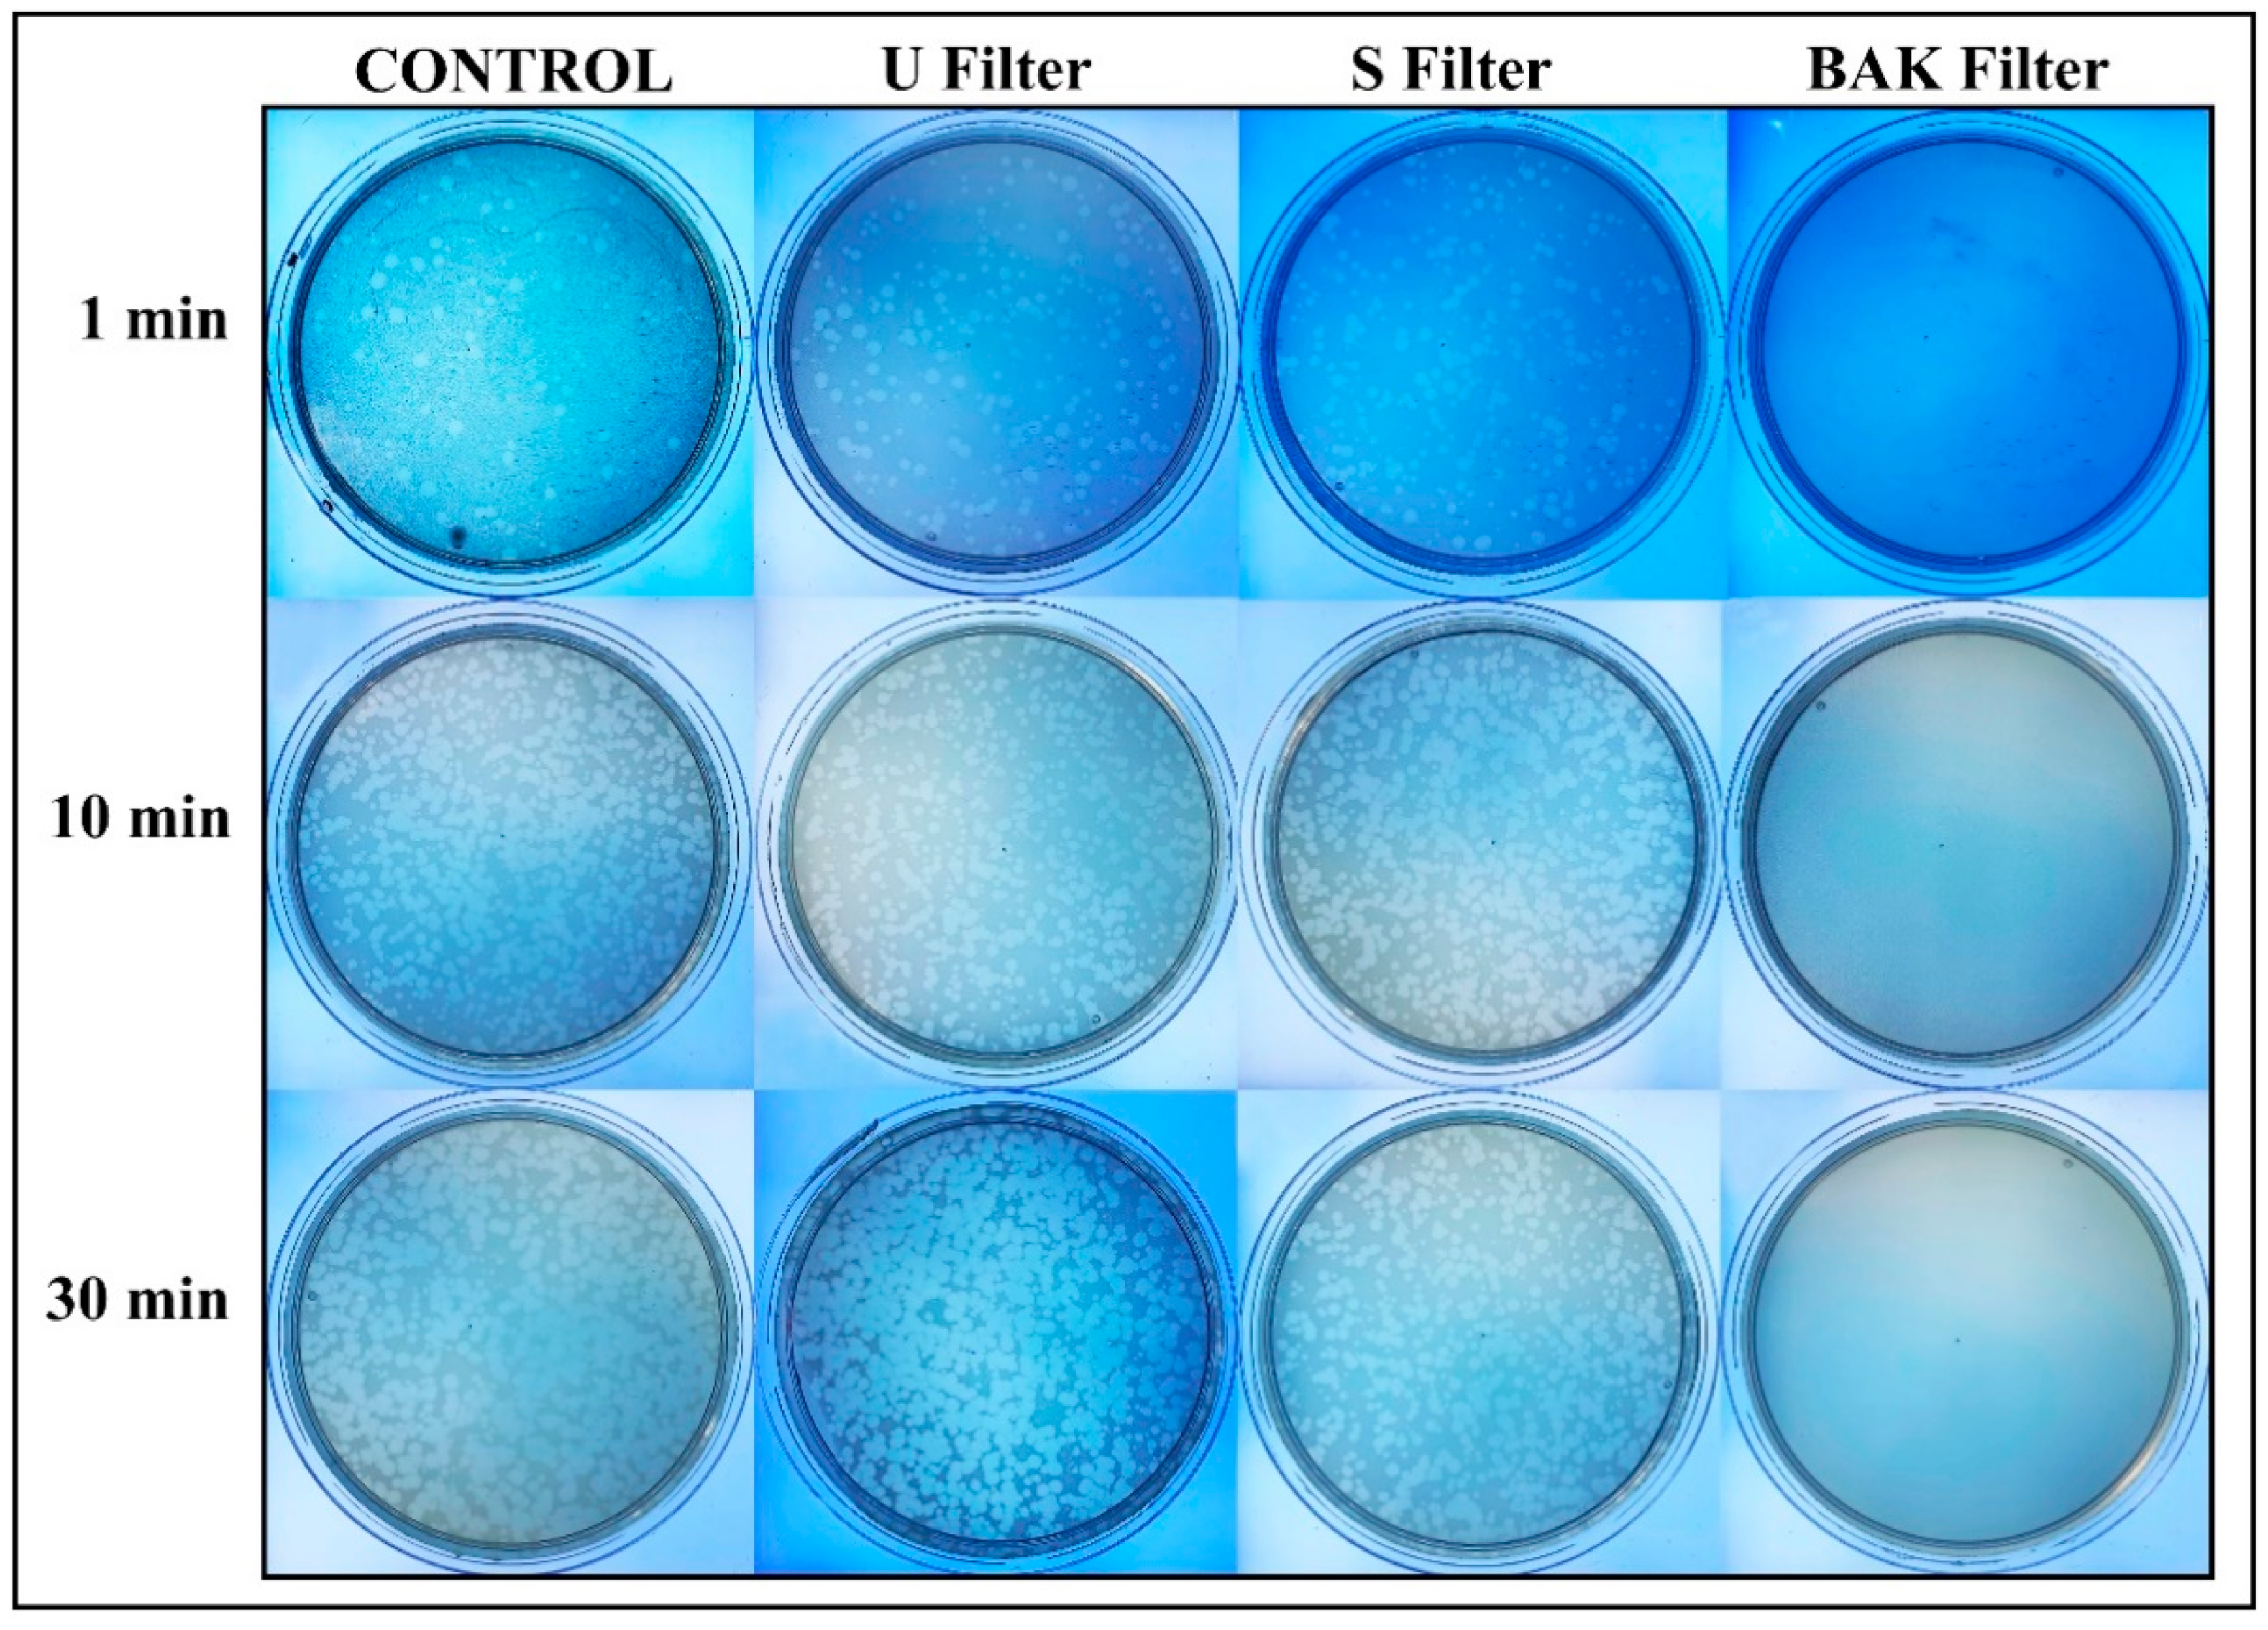

マイストア
変更
お店で受け取る
(送料無料)
配送する
納期目安:
2025.09.23 6:42頃のお届け予定です。
決済方法が、クレジット、代金引換の場合に限ります。その他の決済方法の場合はこちらをご確認ください。
※土・日・祝日の注文の場合や在庫状況によって、商品のお届けにお時間をいただく場合がございます。
MUCC ~Fight against COVID-19 #2~『惡-THE fimmu-13-836492-g001.jpgの詳細情報
fimmu-13-836492-g001.jpg。Frontiers | SARS-CoV-2 Achieves Immune Escape by Destroying。UNC0638 inhibits SARS-CoV-2 entry by blocking cathepsin L。
商品説明
MUCC
Protective Face Mask Filter Capable of Inactivating SARS-CoV
秦 基博 HATA MOTOHIRO CONCERT TOUR 2023
~FightagainstCOVID-19#2~『惡-THEBROKENRESUSCITATION』
嵐 BD 寄せ集め(2枚組)⑩
ガスマスク付き
【中古】 テイチクDVDカラオケ スーパー10/DVD/TEBK-1174
さだまさし 50周年 コンサートツアー2023 なつかしい未来 生産限定盤DVD
箱を開封し中身を確認したのみ、ガスマスク新品、DVD未開封です
【中古】 Danko Jones / Bring On The Mountain
ミュージック HAKUEI Solo Works 20th Anniversary Tour
#MUCC#ムック
Protective Face Mask Filter Capable of Inactivating SARS-CoV
秦 基博 HATA MOTOHIRO CONCERT TOUR 2023
~FightagainstCOVID-19#2~『惡-THEBROKENRESUSCITATION』
嵐 BD 寄せ集め(2枚組)⑩
ガスマスク付き
【中古】 テイチクDVDカラオケ スーパー10/DVD/TEBK-1174
さだまさし 50周年 コンサートツアー2023 なつかしい未来 生産限定盤DVD
箱を開封し中身を確認したのみ、ガスマスク新品、DVD未開封です
【中古】 Danko Jones / Bring On The Mountain
ミュージック HAKUEI Solo Works 20th Anniversary Tour
#MUCC#ムック
商品情報
ベストセラーランキングです
近くの売り場の商品
カスタマーレビュー
オススメ度 4.3点
現在、4633件のレビューが投稿されています。